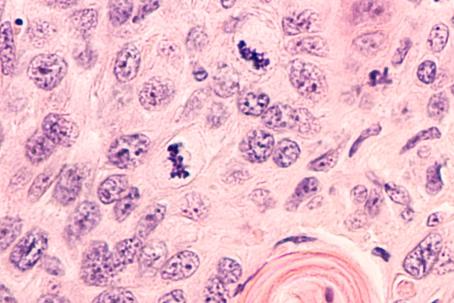
Macro-photograph of cells damaged by a high dose of radiation. (Source: © David A Litman / stock.adobe.com) Macro-photograph of cells damaged by a high dose of radiation. (Source: © David A Litman / stock.adobe.com)

Effects of Ionizing Radiation
5 min read
Ionizing radiation has the ability to ionize matter as it passes through. It liberates electrons from their atoms, ionizing the atoms. This may damage the molecules or lead to structural changes in the matter.
Biological Effects
The ionizing radiation passing through a living cell may damage or even kill it. The damage may be direct (radiation affects the DNA) or indirect (radiation produces free radicals that will subsequently damage the DNA). A cell may repair minor defects, such as damage to one-half of a DNA chain. If the damage cannot be repaired, the cell dies. A single dead cell does not pose any threat to the organism. Damaged DNA that does not lead to cell death may result in mutation and altered behavior of the cell, including all its descendants, and can possibly trigger cancer.
Minor doses of constant radiation do not pose any threat to living organisms since the organism is able to repair all such defects. Slightly elevated doses may increase the risk of cancer. On the other hand, they can trigger body repair mechanisms and the body can then handle the cancerous cells better. This theory is known as hormesis and is based on studies suggesting that people living in areas with higher a natural radiation background suffer less from cancer.
High radiation doses lead to extensive damage of organs, organ failure, and even death.
Technetium is used for about 30 million medical procedures every year.
Use of Biological Effects
The medical effects of low radiation doses are used in radioactive spas around the world. High radiation doses are used to treat tumors. Since cancerous cells divide rapidly, they are more sensitive to radiation than regular body cells. A small self-contained alpha radiation source may be injected into a tumor. Another possibility is to use bundles of gamma beams that intersect in a tumor and burn it (the Leksell gamma knife) or neutrons that release most of their energy when arrested in the tissue, and thus a tumor may be very precisely targeted. High doses may be used to sterilize instruments or irradiate food products. Since radiation kills microorganisms, the food products do not perish and stay fresh longer. Radiation may be also used to limit germination and to kill pests. Cultural monuments may be protected by radiation against woodworm and molds without using chemicals that might cause irreparable damage.
Already since the fifties, mutations that were created thanks to irradiation have been used for cultivation and breeding to create new plant and animal species. For example, the pink seedless grapefruit was created in this way.
Every year, decay, pests, molds, and the premature germination of sowing seeds destroy between 25% and 30% of all food products.
Material Effects and Their Uses
Ions and free radicals produced in matter following its irradiation are chemically very reactive and thus they can cause a whole range of material changes. When applied properly, they can induce desirable physical, chemical, electrical, and other properties. Radiation technology is used in chemistry to make polymer foams, to vulcanize rubber, or for radio synthesis (where ionizing radiation is used as a chemical reaction catalyst). Radiation can be also used to harden paint, change the properties of fabric (its color, dyeability and absorption), and make laminates by the polymerization of thin layers. It is possible to make materials with brand new properties without using any undesirable chemical additives that would bring about such a change. The color of glass can also be changed by radiation to make brand new shades. Ionizing radiation in semiconductors changes the life span of a charge carrier, enabling the growth of silicone and other crystals exhibiting properties otherwise unattainable. The memory effect induced in irradiated products made of polyethylene is used to make heat-shrink materials.
Photocopiers use a trace amount of radioisotope in order to minimize static electricity and prevent the papers from sticking together.
Radiation embrittlement caused by radiation may alter the structure of metals. That is why the nuclear reactor vessel must be made of a special alloy so that it can withstand a neutron stream for up to eighty years.